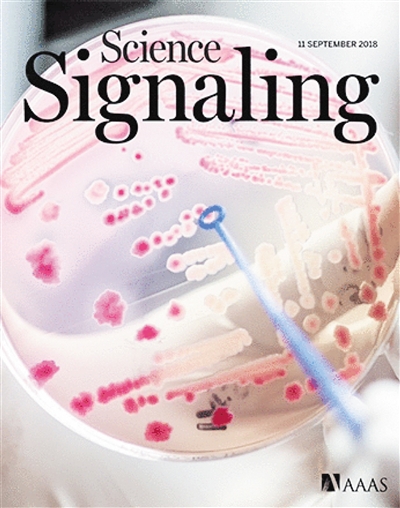
image002.jpg

行业资讯
小分子伊曲泼帕攻克骨髓衰竭难题
小分子伊曲泼帕攻克骨髓衰竭难题

《科学·转化医学》
2018.9.12
慢性血小板减少可能与骨髓衰竭综合征和免疫紊乱等多种病症相关,它增加了严重出血的风险,而血小板输注或重组血小板生成素的治疗又会产生各种并发症。相比之下,血小板生成素受体拮抗剂小分子伊曲泼帕(eltrombopag)治疗骨髓衰竭患者的血小板减少症方面非常有效。美国阿尔伯特·爱因斯坦医学院细胞生物学系的科学家最新研究表明,伊曲泼帕除了靶向血小板生成素受体外,还能与铁螯合,这种螯合作用使其能够改善骨髓干细胞的功能。研究还确定了铁螯合与造血干细胞的联系机制,或为未来治疗提供新的思路。
成神经管细胞瘤治疗新靶点找到
《科学·信号》
2018.9.11
成神经管细胞瘤是一种侵袭性脑肿瘤,多发于儿童,一直缺乏靶向治疗方案。由音猬因子(SHH,一种信号传导分子)活性所驱动的亚型对目前的药物如原癌基因(SMO)抑制剂,尤其具有耐药性。德国图宾根大学国际细胞生物学研究所马加斯梅尼基斯等科学家,利用磷酸化蛋白质组学追踪了引起成神经管细胞瘤的小鼠的细胞发育,并确定了酪蛋白激酶2(CK2)可能是一种治疗靶点。CK2抑制剂阻断了SHH型人和小鼠成神经管细胞瘤细胞的生长,显著延长了患瘤小鼠的生存期,该药物耐受良好。其中一种化合物还阻止了CK2突变肿瘤的生长,这表明它对常见的耐药模式不那么敏感。目前在儿科患者中测试这种抑制剂的临床试验正在开展。
微生物种群进化伴随大量有益突变

《遗传学趋势》
2018.9.1
在实验室研究微生物进化的实验中,进化动力学异常复杂。本期封面文章, 美国哈佛大学生物与进化生物学学系伊凡娜等科学家讨论了在实验室对微生物进化的动力学进行观察的最新进展。近年来,在高通量菌株维持和表型分析方面的进展,使得基因组测序的成本大幅降低,以及谱系条码的新兴方法,使得观察进化动力学的分辨率大幅提高。实验室研究表明,即使在简单的恒定环境中,微生物种群为快速适应,仍会产生有益的大量突变。这些类型的实验现在可被用来理解一系列系统中适应性和进化结果的关键方面。
(本栏目主持人:陆成宽)